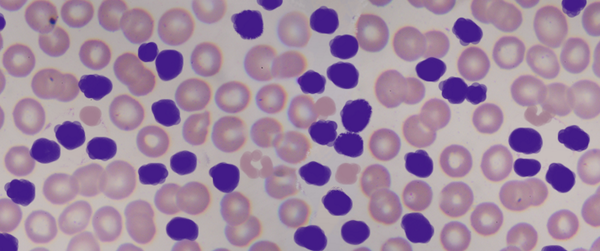
FDA_Drug_Info's tweet image. FDA approves Zydelig for three types of blood cancers. go.usa.gov/5US5

LLS NM/El Paso
@LLSNM
Our mission: cure leukemia, lymphoma, Hodgkin's disease and myeloma, and improve the quality of life of patients and their families.
You might like
You raised $300k in 30 days! THANK YOU for helping fund our goal of a world without blood cancers! #Raise4LLS

LLS advocates make a big difference. Take action at lls.org/bcam14 - then share with your friends!

New blog on @LLSUSA funded research impacting #breastcancer: bit.ly/1miljv3. Original from @sciencemagazine: scim.ag/1AR3VAy
YOU are funding the end of blood cancers! bit.ly/BCAM14 #Raise4LLS14

YOU CAN change the landscape of cancer treatment by helping us fund researchers like Dr. Carl June. bit.ly/1u8dabs #Raise4LLS14
We are incredibly proud of our 2014 Boy of the Year and star athlete Kody Smith! goo.gl/PkT9od @KOATLiveUpdates @JerryRice
YOU CAN help all blood cancer patients survive! More than 1/3 of blood cancer patients don't survive. bit.ly/BCAM14 #Rasie4LLS14
YOU CAN raise $300k in 30 days & help fund clinical specialists: bit.ly/BCAM14 #Raise4LLS14

Thank you @Gov_Martinez for supporting our mission & proclaiming Sept 2014 as Blood Cancer Awareness Month in NM!

Speak up for blood cancer patients in a letter to the editor today. advocacy.lls.org/letter/?letter… #LLS

FDA approves Zydelig for three types of blood cancers. go.usa.gov/5US5
This is a something you do everyday, and it increases your risk of cancer by 66% #cancer time.com/2884953/sittin…
Congrats to La Cueva - the #1 LLS fundraising high school in NM/El Paso this year! Outstanding! @MrResch @ABQschools

Way to go, Georgia O'Keeffe ES, raising $ 4237.78 for #PenniesForPatients this year! Amazing job! @ABQschools

What an incredible meeting with Lauren Arias @SenatorTomUdall's office! Thank your supporting access to lifesaving treatments! #ideclare4LLS
Thank you Scott Stockwell at @repbenraylujan's office for meeting with us to address specialty tiers affecting New Mexicans! #ideclare4LLS
Thank you Courtney for meeting with LLS again this year! We appreciate the support of @RepLujanGrisham #ideclare4LLS

Major thanks to Lauren Arias in the office of @SenatorTomUdall for a great meeting 2 years in a row! #ideclare4LLS

Such a pleasure to meet with Courtney Weaver at @RepLujanGrisham's office. Thank you for your continuing support! #ideclare4LLS
Thank you Louis Agnello at the office of @MartinHeinrich for an encouraging meeting and your support of our mission #ideclare4LLS
United States Trends
- 1. Ryan Garcia N/A
- 2. #UFCHouston N/A
- 3. Strickland N/A
- 4. Rondale Moore N/A
- 5. Rockets N/A
- 6. Knicks N/A
- 7. Duke N/A
- 8. AJ Dybantsa N/A
- 9. Brunson N/A
- 10. Greenland N/A
- 11. Auburn N/A
- 12. Fluffy N/A
- 13. UCLA N/A
- 14. Michigan N/A
- 15. #Boxing N/A
- 16. Mark Pope N/A
- 17. Chandler N/A
- 18. Jose Alvarado N/A
- 19. Frank Martin N/A
- 20. Albright N/A
You might like
Something went wrong.
Something went wrong.


























































